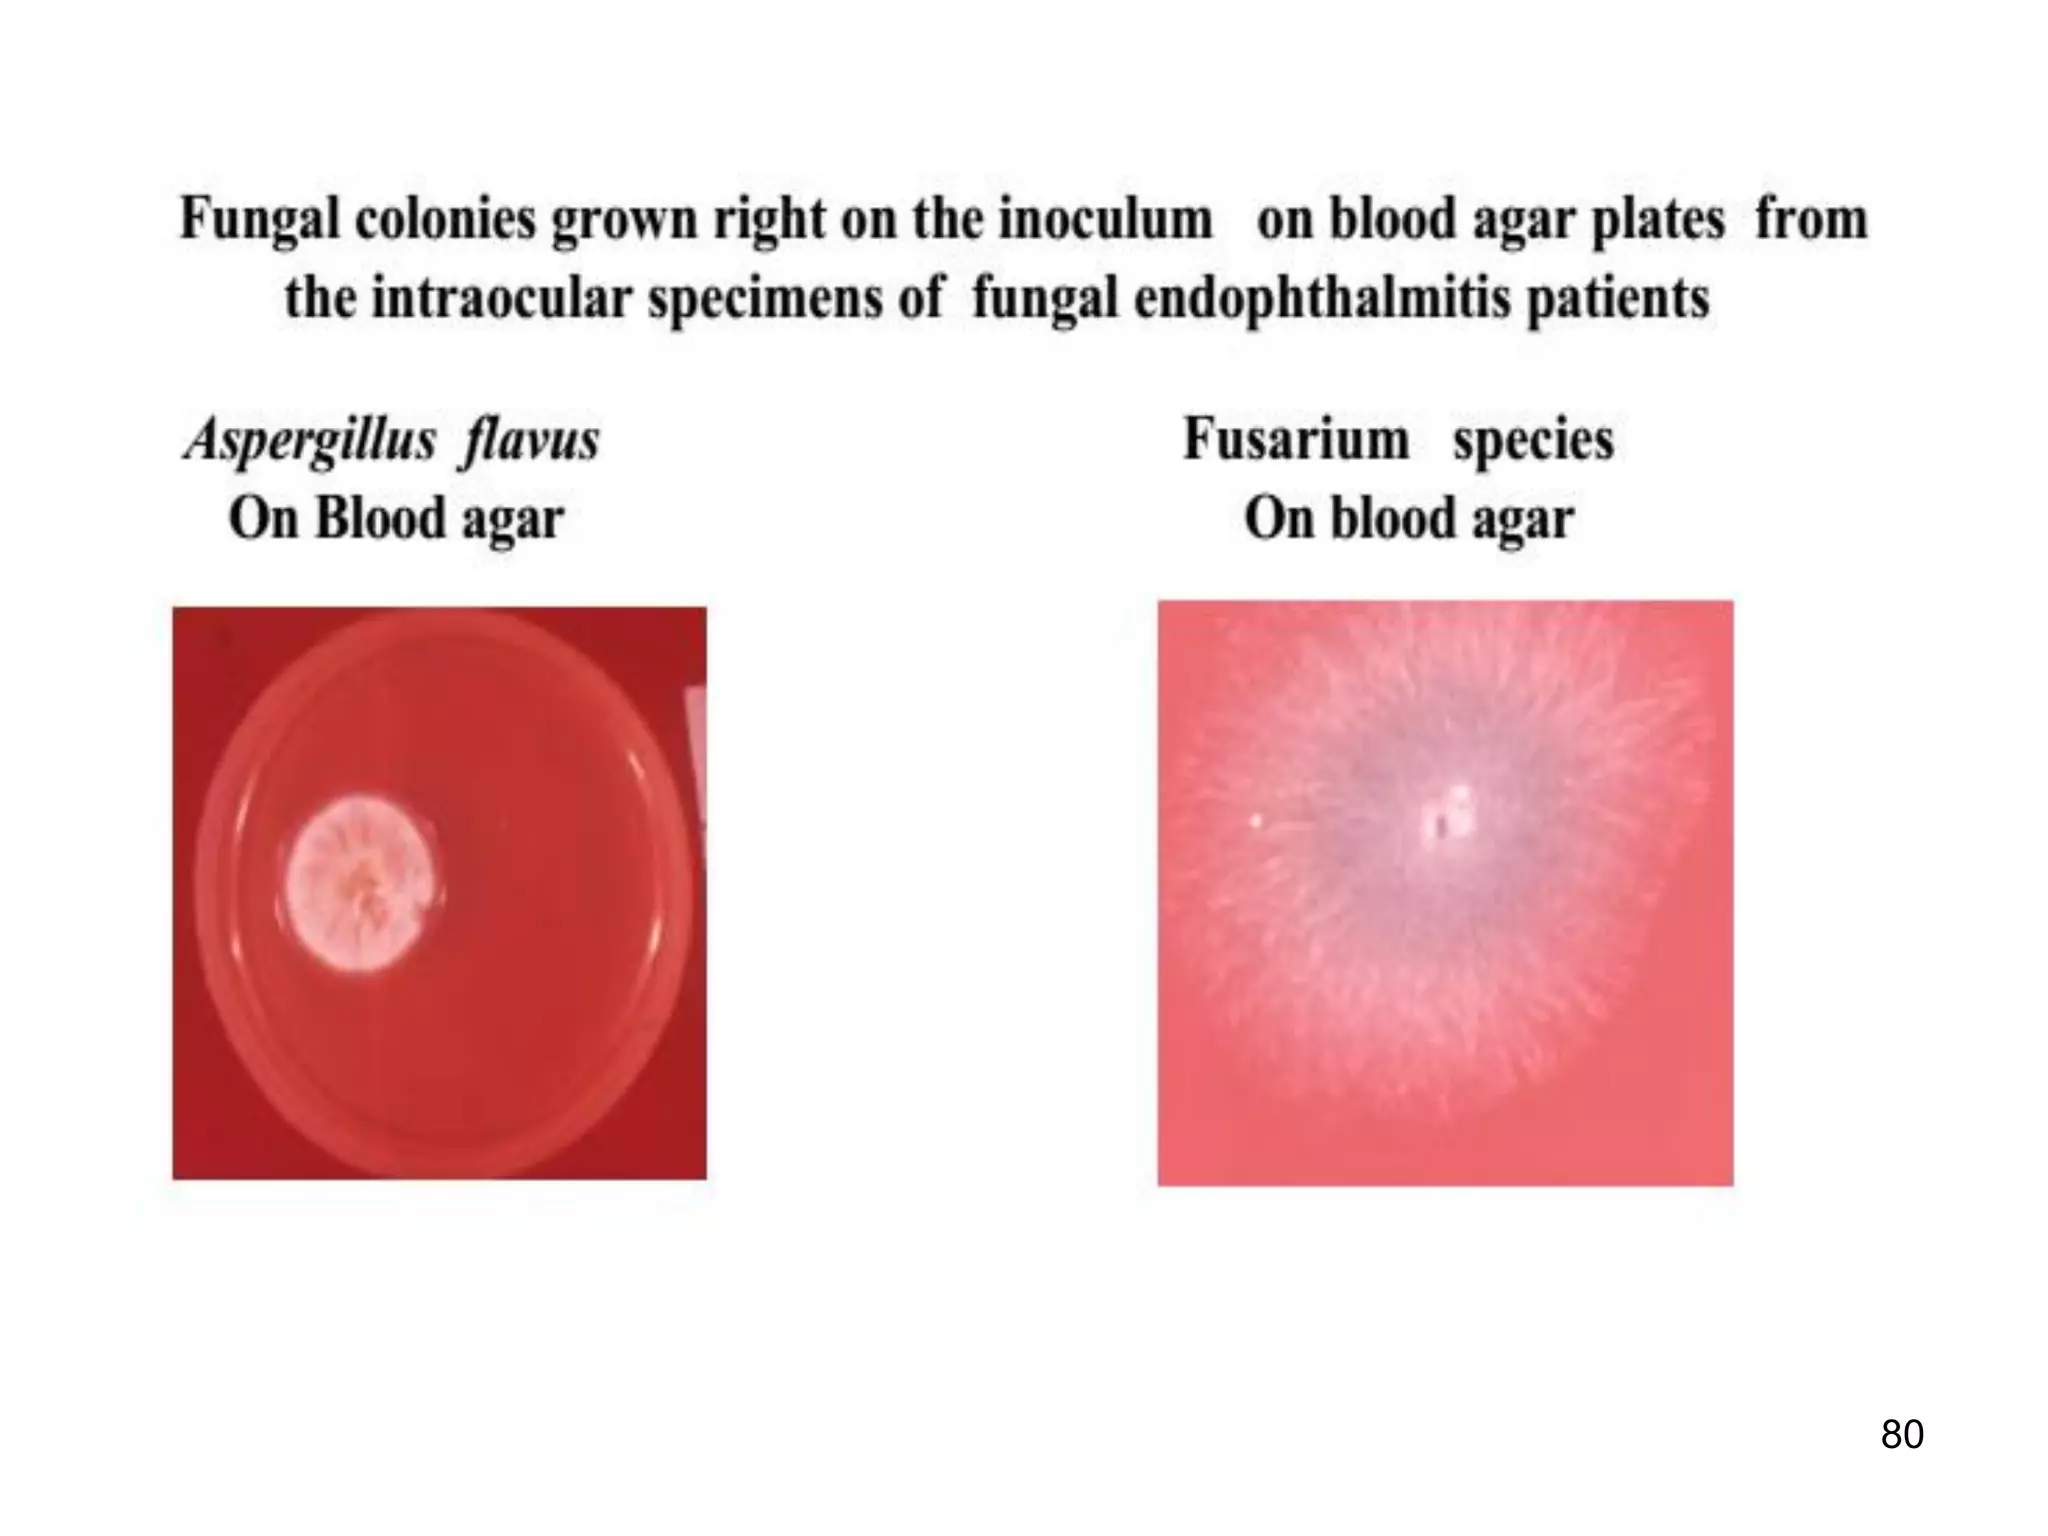
80

This document discusses ocular microbiology. It begins by outlining the teaching objectives which are to describe common eye pathogens, the diseases they cause, and their transmission, prevention and treatment. It then provides an overview of common eye infections like blepharitis, dacryocystitis, conjunctivitis and their causes. Specific pathogens discussed include bacteria like Staphylococcus, viruses like herpes and adenovirus, and parasites that cause trachoma and river blindness. Laboratory diagnosis of conditions like blepharitis and conjunctivitis is also summarized.